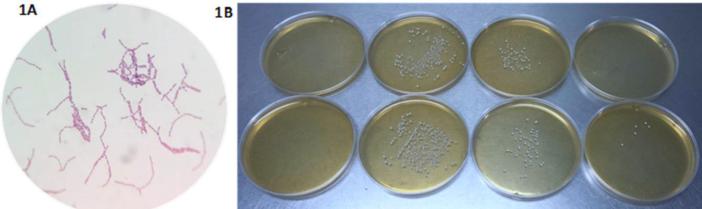
https://cdn.ncbi.nlm.nih.gov/pmc/blobs/c7d7/7110305/160c9aae1bdb/gr1.jpg

使用椰子水()开发一种共生功能性饮料。
Use of coconut water () for the development of a symbiotic functional drink.
作者信息
Segura-Badilla Orietta, Lazcano-Hernández Martín, Kammar-García Ashuin, Vera-López Obdulia, Aguilar-Alonso Patricia, Ramírez-Calixto Joaquín, Navarro-Cruz Addí Rhode
机构信息
Facultad de Ciencias de la Salud y de los Alimentos, Departamento de Nutrición y Salud Pública, Programa UBB Saludable, Universidad del Bío-Bío, Chile.
Facultad de Ciencias Químicas, Departamento de Bioquímica y Alimentos, Benemérita Universidad Autónoma de Puebla, Mexico.
出版信息
Heliyon. 2020 Mar 28;6(3):e03653. doi: 10.1016/j.heliyon.2020.e03653. eCollection 2020 Mar.
Many studies suggest that probiotic, prebiotic and symbiotic foods may be beneficial in the prevention and management of nutrition and health, the objective of this work was to develop a symbiotic drink based on coconut water. Fermentation was performed using lyophilized SP1 and inulin as a source of soluble fiber. Different formulations were developed, determining the concentrations of fiber and probiotics. The growth of the probiotic in MRS broth was evaluated, using the plate counting technique in different periods of time. The fermentation time of the drink was 8 h and the shelf life in refrigeration was 14 days evaluated by pH and hedonic scale. The pH of the final drink was 3.48 and the probiotic content was 82 × 10 CFU/ml. It is concluded that coconut water can be processed by adding probiotic and prebiotic characteristics with sensory acceptance and adequate preservation characteristics.
许多研究表明,益生菌、益生元和合生元食品可能对营养与健康的预防和管理有益,这项工作的目的是开发一种基于椰子水的合生元饮料。使用冻干的SP1和菊粉作为可溶性纤维来源进行发酵。开发了不同的配方,确定了纤维和益生菌的浓度。采用平板计数技术在不同时间段评估益生菌在MRS肉汤中的生长情况。通过pH值和喜好程度量表评估,饮料的发酵时间为8小时,冷藏保质期为14天。最终饮料的pH值为3.48,益生菌含量为82×10CFU/ml。结论是,通过添加益生菌和益生元特性,椰子水可以加工成具有感官接受度和足够保存特性的产品。